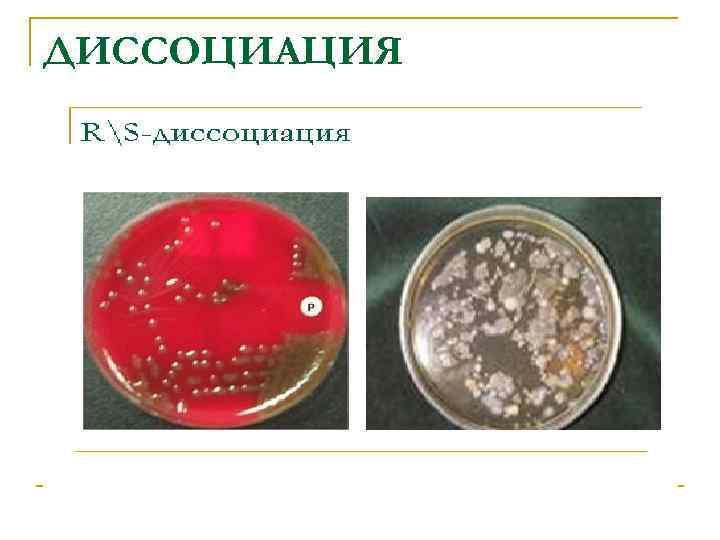
ДИССОЦИАЦИЯ

Лекция 7. Генетика микроорганизмов.ppt
- Количество слайдов: 32

ГЕНЕТИКА МИКРООРГАНИЗМОВ

ОРГАНИЗАЦИЯ ГЕНЕТИЧЕСКОГО АППАРАТА - Бактериальный геном состоит из репликонов - РЕПЛИКОНЫ – генетические элементы, способные к самостоятельной репликации (воспроизведению)

Репликонами являются бактериальная хромосома и плазмиды

n n Наследственная информация хранится у бактерий в форме последовательности нуклеотидов ДНК, которые определяют последовательность аминокислот в белке Каждому белку соответствует свой ген, т. е. дискретный участок на ДНК, отличающийся числом и специфичностью последовательности нуклеотидов

Бактериальная хромосома n n представлена одной двухцепочечной молекулой ДНК кольцевой формы имеет гаплоидный набор генов

Подвижные генетические элементы - Вставочные (инсерционные) генетические элементы IS – элементы (insert – вставка, sequence – последовательность) – участки ДНК, способные перемещаться из одного участка репликона в другой или между репликонами

Транспозоны n участки ДНК, обладающие свойствами IS –элементов и имеющие структурные гены, обеспечивающие синтез веществ, обладающих специфическим биологическим свойством

Подвижные генетические элементы вызывают n n n Инактивацию генов тех участков ДНК, куда они, переместившись, встраиваются ( «выключение» генов) Образование повреждений генетического материала (мутации) Слияние репликонов, т. е. встраивание плазмиды в хромосому

ПЛАЗМИДЫ n n Это двухцепочечные молекулы ДНК, которые кодируют не основные для жизнедеятельности бактерий функции Придают бактерии преимущества при попадании в неблагоприятные условия существования

ФУНКЦИИ ПЛАЗМИД n n Регуляторная – состоит в компенсации нарушений метаболизма ДНК клетки хозяина Кодирующая – состоит во внесении в бактериальную клетку новой информации, о которой судят по приобретённому признаку

КЛАССИФИКАЦИЯ ПЛАЗМИД n n Интегративные плазмиды (эписомы) – могут обратимо встраиваться в бактериальную хромосому и функционировать в виде единого репликона Трансмиссивные или конъюгативные плазмиды – способны передаваться из одной клетки в другую

РАЗЛИЧАЮТ n n F – плазмиды контролируют синтез половых пилей R – плазмиды содержат гены, детерминирующие синтез ферментов, разрушающих антибактериальные препараты Плазмиды патогенности контролируют вирулентные свойства бактерий Бактериоциногенные плазмиды

ЗНАЧЕНИЕ ПЛАЗМИД В ГЕНЕТИЧЕСКОЙ ИНЖЕНЕРИИ n n Генетическая инженерия сводится к генетическим рекомбинациям Метод рекомбинации in vitro заключается: 1 – в выделении или синтезе ДНК из отличающихся друг от друга организмов или клеток 2 – получении гибридных молекул ДНК 3 – введении рекомбинантных (гибридных) молекул в живые клетки 4 – в создании условий для экспрессии и секреции продуктов, кодируемых генами

n n n Гены, кодирующие те или иные структуры выделяют с помощью ферментов рестрикции Полученный целевой ген с помощью ферментов лигаз сшивают с другим геном, который используется в качестве вектора (векторы плазмиды, бактериофаги) Экспрессируемый ген в виде рекомбинантной ДНК встраивается в клетку, которая приобретает новое свойство – продуцировать несвойственное этой клетке вещество, кодируемое экспрессируемым геном

n n В качестве реципиентов чаще всего используют Escherichia coli, дрожжи, вирусы В медицине применяют полученные методом генетической инженерии вакцины против гепатита В; интерлейкины-1, -2, -3; инсулин; гормоны роста; интерфероны α, β, γ; фактор свёртываемости крови; многие антигены для диагностических целей



МОДИФИКАЦИИ n n Фенотипические изменения какого-либо признака или нескольких признаков микроорганизма Не сопровождаются изменениями первичной структуры ДНК и вскоре утрачиваются

ПРИМЕРЫ МОДИФИКАЦИЙ n n n L-трансформация Включение «молчащих» генов некоторых микроорганизмов, в результате чего происходит смена их Аг в ходе инфекционного заболевания (напр. , боррелии – возбудители возвратных тифов) Стафилококки только в присутствии пенициллина синтезируют фермент, разрушающий данный антибиотик

ДИССОЦИАЦИЯ n Возникает вследствие образования 2 -х форм бактериальных клеток, которые отличаются друг от друга по характеру образуемых ими колоний на твёрдой питательной среде

ХАРАКТЕРИСТИКА КОЛОНИЙ n n S - колонии (англ. smooth – гладкий) круглые, влажные, с блестящей гладкой поверхностью и ровными краями R – колонии (англ. rough - неровный, грубый) – неправильной формы, непрозрачные, сухие, с неровными краями и шероховатой поверхностью
ДИССОЦИАЦИЯ

ГЕНОТИПИЧЕСКАЯ ИЗМЕНЧИВОСТЬ

МУТАЦИИ n Изменения в первичной структуре ДНК, которые выражаются в наследственно закреплённой утрате или изменении какоголибо признака (признаков)

КЛАССИФИКАЦИЯ МУТАЦИЙ По протяжённости изменений: n ТОЧЕЧНЫЕ – повреждения ограничиваются одной парой нуклеотидов n ПРОТЯЖЁННЫЕ (АБЕРРАЦИИ): делеции – выпадение пар нуклеотидов дупликации – добавление нуклеотидов транслокации – перемещение нуклеотидов инверсии – перестановка нуклеотидных пар

ПО ПРОИСХОЖДЕНИЮ n n Спонтанные мутации возникают самопроизвольно Индуцированные мутации происходят с гораздо большей частотой , возникают в результате воздействия мутагенов: - физических – УФ-лучи, γ-радиация - химических – аналоги пуриновых и пиримидиновых оснований - биологических - транспозоны

РЕКОМБИНАЦИИ n Форма обмена генетическим материалом между двумя отдельными бактериями

МЕХАНИЗМЫ РЕКОМБИНАЦИИ n КОНЪЮГАЦИЯ – обмен генетическим материалом (хромосомным или плазмидным), осуществляется при непосредственном контакте клетки донора и реципиента. После образования между донором и реципиентом конъюгационного мостика одна нить ДНК-донора поступает по нему в клетку-реципиент

n ТРАНСДУКЦИЯ – это передача генетической информации между бактериальными клетками с помощью умеренных трансдуцирующих фагов, которые могут переносить один или более генов


n ТРАНСФОРМАЦИЯ – передача генетической информации в виде изолированных фрагментов ДНК при нахождении реципиентной клетки в среде, содержащей ДНК донора

Лекция 7. Генетика микроорганизмов.ppt